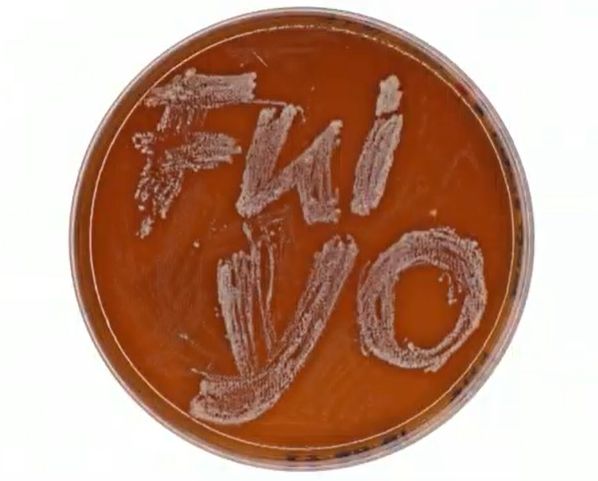

MicroMundosLo invisible que Sostiene la Vida
Conoce MicroMundos, la exposición de arte que invita al público a adentrarse en los mundos invisibles que habitan entre nosotros. A través de una experiencia educativa que une arte y ciencia, la muestra busca revelar el papel fundamental de los microorganismos. Esta exposición hará visible esa compleja red de vida microbiana mediante recursos visuales, ilustraciones científicas y proyecciones que permitan al visitante observar y comprender su importancia.







MICROMUNDOS
Fechas importantes
¡No te pierdas nada! Revisa las fechas clave de Micromundos.
- Pre-inauguración: 2 de agosto de 2025
- Montaje: Lunes 4 de agosto de 2025
- Inauguración: Martes 5 de agosto de 2025
- Clausura: Domingo 10 de agosto de 2025

MicroMundos
Conoce la Exposición
El blanqueamiento de los corales fin de la relación simbiótica de las especies
Artista: Aranza Montserrat Martínez González
Técnica: Acuarela sobre papel y lápices de colores
Año: 2025
Año: 2025
MUSEO ITINERANTE: UNA ESTRATEGIA PARA APRENDER DE LA BIODIVERSIDAD NO VISIBLE
Artista:Fabiana María Lora Súarez , Nelsy Loango Chamorro y Elizabeth Coronado García
Técnica:Técnica que utiliza microorganismos como trazos vivos sobre medios de cultivo, donde su crecimiento dibuja formas únicas. Estas obras, una vez desarrolladas, son fijadas y resinadas, preservando la belleza del mundo microbiano en una expresión artística perdurable
Año: 2025
Técnica:Técnica que utiliza microorganismos como trazos vivos sobre medios de cultivo, donde su crecimiento dibuja formas únicas. Estas obras, una vez desarrolladas, son fijadas y resinadas, preservando la belleza del mundo microbiano en una expresión artística perdurable
Año: 2025